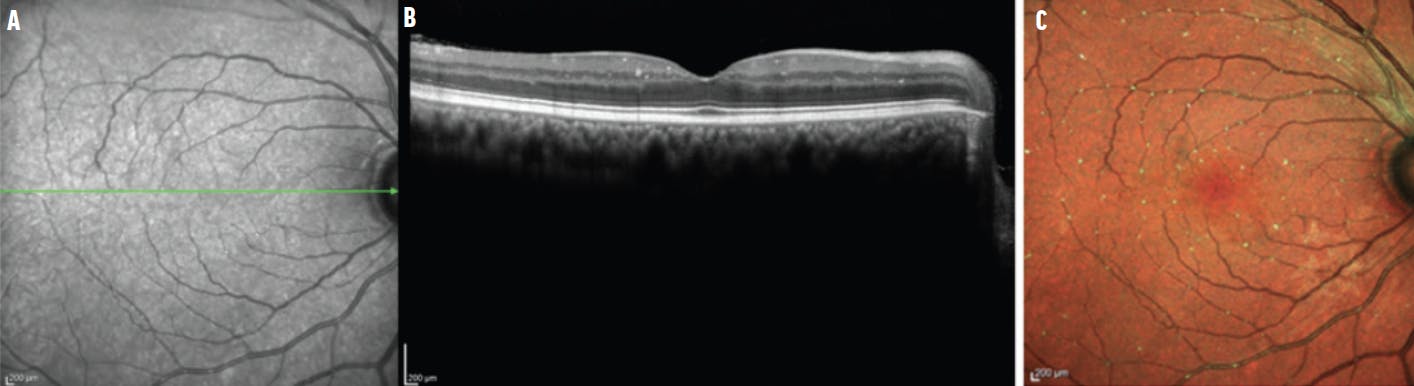
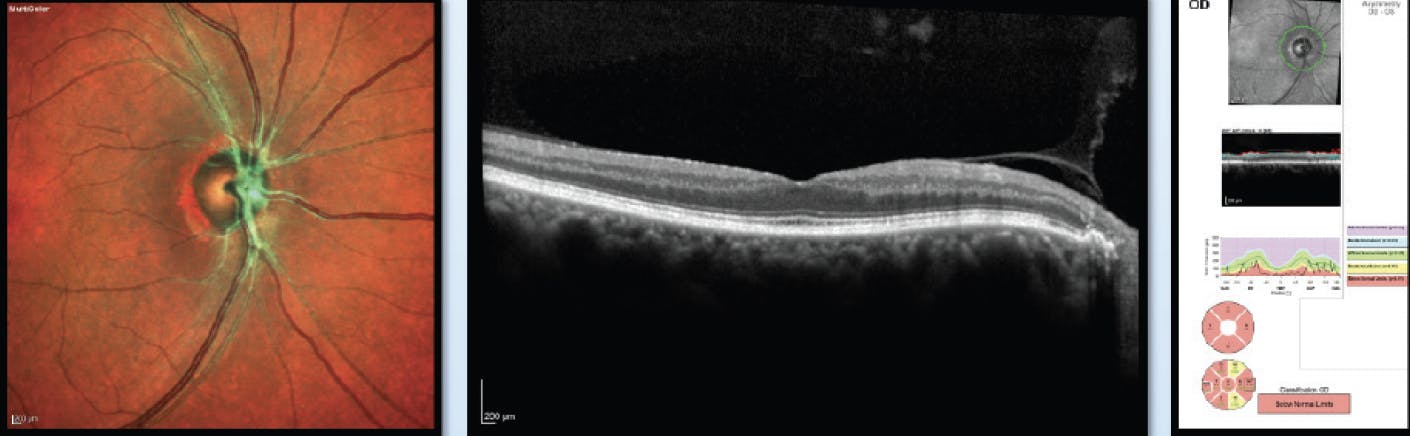

Today’s advanced imaging capabilities make the invisible visible, going beyond what we can see with traditional ophthalmoscopy and fundus photography. We can detect ischemia, find emboli in retinal arteries, and gain new insight into neuromyelitis optica and other unusual cases of ischemic optic neuropathy. This has public health implications beyond ophthalmology, in terms of the existence and effect of underlying health conditions such as atrial fibrillation and predicting stroke risk.
In my practice, I have implemented many tools, including a variety of imaging platforms. One of these tools is multicolor OCT imaging (Spectralis, Heidelberg Engineering). Here, I share three instances where advanced imaging has helped me to diagnose and manage patients with systemic disease.
HOW IT WORKS
Multicolor imaging uses three varying wavelengths of light to create fundus images (Figure 1). The short blue wavelength accentuates the structures in the superficial retina, the slightly longer green wavelength helps to visualize structures within the mid-retina, and the longest wavelength—infrared—provides visualization of structures that are near the outer retina and choroid. A fourth composite image merges the reflectance images of all three wavelengths, providing a depth-resolved fundus image. This means clinicians must learn to interpret multicolor images differently from fundus photography.

Figure 1. These multicolor OCT images depict ischemic branch RVO. Different wavelength views are indicated by the color of the outline (A, B, C). Here, the best view of the RVO is with the green wavelength. In the composite, the retinal artery is very narrow, then turns green (D). Images courtesy of David Iain Clark, MD.
Multicolor OCT does require dilation of the pupils and the light is rather bright, but otherwise the procedure is noninvasive, noncontact, and painless.
SYSTEMIC CONDITIONS MANIFESTING IN THE EYE
Emboli and Vaso-occlusive Disease
This technology can help enhance our ability to detect emboli and vaso-occlusive disease and informs our management approach (Figure 2). If the patient is older than 55 years of age, we must also consider the higher likelihood of giant cell arteritis as a diagnostic differential. If the patient has evidence of an embolic event, however, we must be on the alert for the risk of stroke. Researchers found that patients with an incidence of central retinal artery occlusion (CRAO) are at an increased risk of an ischemic stroke just after the occurrence with the risk increasing to 120% during the first week immediately following the CRAO.1
Figure 2. These images are from a patient with amaurosis fugax patient and emboli. While not clearly visible in the infrared image (A), white particles appear on the OCT line scan (B). They extend to the outer plexiform layer, the terminal capillaries of the central retinal artery. With multicolor imaging, multiple talc emboli can be seen (C).
Neuromyelitis Optica Spectrum Disorder
Neuromyelitis optica spectrum disorder (NMOSD), also known as Devic’s disease, is a chronic disorder of the brain and spinal cord dominated by optic neuritis and myelitis.2 Typically, NMOSD is unilateral although it can be bilateral. We originally thought these patients only had bad neuritis. However, multicolor OCT imaging shows that patients with NMOSD who have poor visual recovery develop an immunologically driven CRAO (Figure 3).
Figure 3. These images show a patient who was seropositive for NMOSD. With CRAO and no current emboli, the green branches of the central retinal artery are consistent with CRAO and retinal ischemia. The multicolor imaging helps detect neuromyelitis optica along with peripheral blood aquaporin-4 antibody titer.
Based on histopathology, we now know that NMOSD is an autoimmune astrocyte disease,3 and we know that the retina has a large astrocyte population, especially in the Müller cells. In addition, other retinal cells can express aquaporin. When neuroradiologists look closely at the spinal imaging of patients with NMOSD, they will often see an ischemic pattern. Using multicolor OCT imaging, we now know that what is happening in the spinal cord with strokes also happens in the retina.
The other characteristic finding of NMOSD is transverse myelitis, which may be indistinguishable from other cases of “idiopathic” transverse myelitis. Early in the course of the disease, it may be difficult to distinguish between NMOSD and multiple sclerosis (MS) because both can cause optic neuritis and myelitis. However, optic neuritis and myelitis tend to be more severe in NMOSD; the brain MRI is more commonly normal, and the spinal fluid analysis does not usually show oligoclonal bands in NMOSD, which are features that help distinguish it from MS. NMOSD optic neuritis has a much poorer prognosis than MS optic neuritis, and the retina multicolor and OCT show that patients with NMOSD have greater retinal nerve fiber layer and ganglion cell loss than MS patients.
Dermatomyositis
The team at my clinic used multicolor imaging to help find dermatomyositis in a 50-year-old man with pronounced papillitis with diminished venous outflow and vitreous inflammation.4 In this patient, after the swelling started to resolve, we saw a green signal on multicolor OCT, indicating that there was a vascular component to the process. We also saw a central cup, an uncommon finding in nonarteritic ischemic optic neuropathy, which led us to refer the patient to rheumatology. The patient was found to have a positive titer for dermatomyositis.
This case suggests that rapidly progressive optic disc edema with associated inflammation and venous stasis requires a broad workup for infectious, hypercoagulable, and autoimmune etiologies for targeted therapy and visual preservation.4 Because of the timely diagnosis, the patient was able to receive continuing care for his underlying disease rather than just identifying this as a standard case of nonarteritic ischemic optic neuropathy (Figure 4).

Figure 4. The OCT and corresponding 24-2 Humphrey visual field of the right eye of a 50-year-old man show optic disc edema and superior hemifield depressions prior to initiation of pulse dose intravenous steroids (A). The multicolor imaging depicts the pronounced optic disc edema (B). Five months after treatment with intravenous steroids and after stopping oral steroids, the patient’s imaging shows resolution of the optic disc edema (C, D), although there are persistent superior visual field defects.
FINAL THOUGHTS
I have found that this imaging technology can be helpful in understanding unusual cases of optic nerve swelling, often leading to a diagnosis. It is always our job to find those 5% or 10% of cases that are atypical, not just put patients in the largest category of disease for their age and gender. The multicolor imaging arteriole green signal may be a biomarker that can enable emboli detection. It can also help us find CRAO in cases of cryptic visual loss and further refine our diagnosis and management of NMOSD. With the technology, we can work toward defining ischemic processes in the optic nerve and retina.
1. Park SJ, Choi NK, Yang BR, et al. Risk and risk periods for stroke and acute myocardial infarction in patients with central retinal artery occlusion. Ophthalmology. 2015;122(11):2336-2343.e2.
2. Weinshenker B. Neuromyelitis optica spectrum disorder. NORD. Accessed June 10, 2022. https://rarediseases.org/rare-diseases/neuromyelitis-optica
3. Fujihara K. Neuromyelitis optica spectrum disorders: still evolving and broadening. Curr Opin Neurol. 2019;32(3):385-394.
4. Wu CM, Dunn JP, Sergott RC. Papillitis with retinal venous congestion and intraocular inflammation. Am J Ophthalmol Case Rep. 2020;20:100913.































